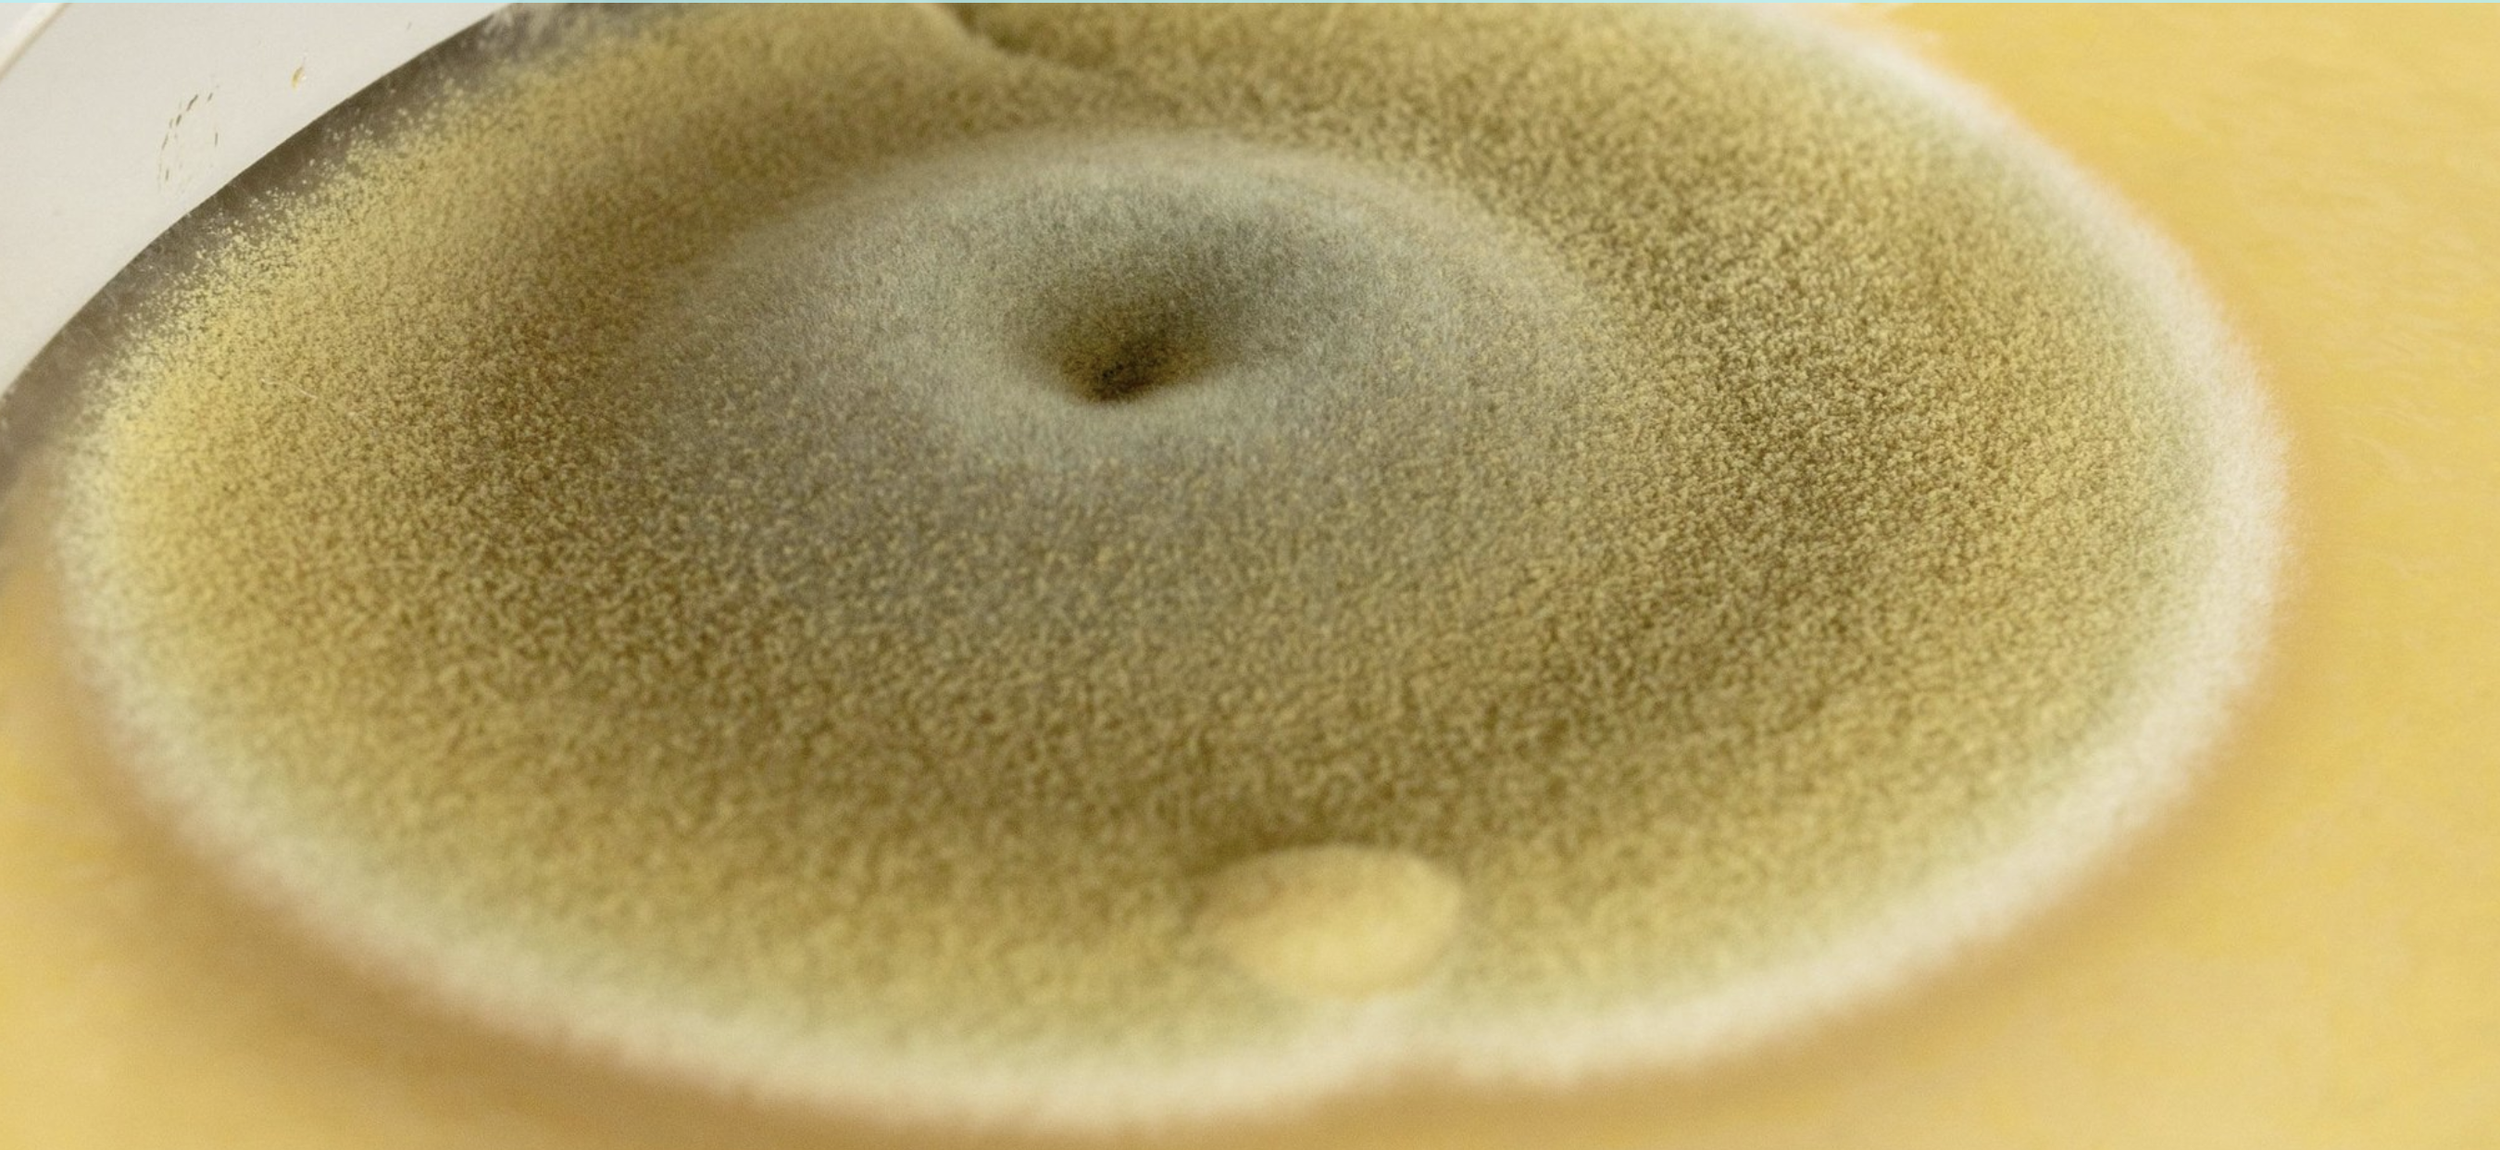

Making Time
Making Time is a research programme that supports artists to experiment with repositioning the planet as a primary stakeholder in their practice. Without prescribed outcomes, the programme champions new material possibilities, environmental sustainability, and behavioural change in the sector.
Over 18-months, Claire Baily, Taey Iohe, Nastassja Simensky & Undead Matter will be supported in their research by Artangel and a network of gallery and academic partners.
Making Time is devised by Artangel and produced in partnership with Science Gallery London at King's College London. The programme is supported by Radar at Loughborough University, Warwick Institute of Engagement at University of Warwick and Stanley Picker Gallery at Kingston University.
Credits and Funding
Artangel is generously supported using public funding by Arts Council England, and by the private patronage of The Artangel International Circle, Special Angels and The Company of Angels.